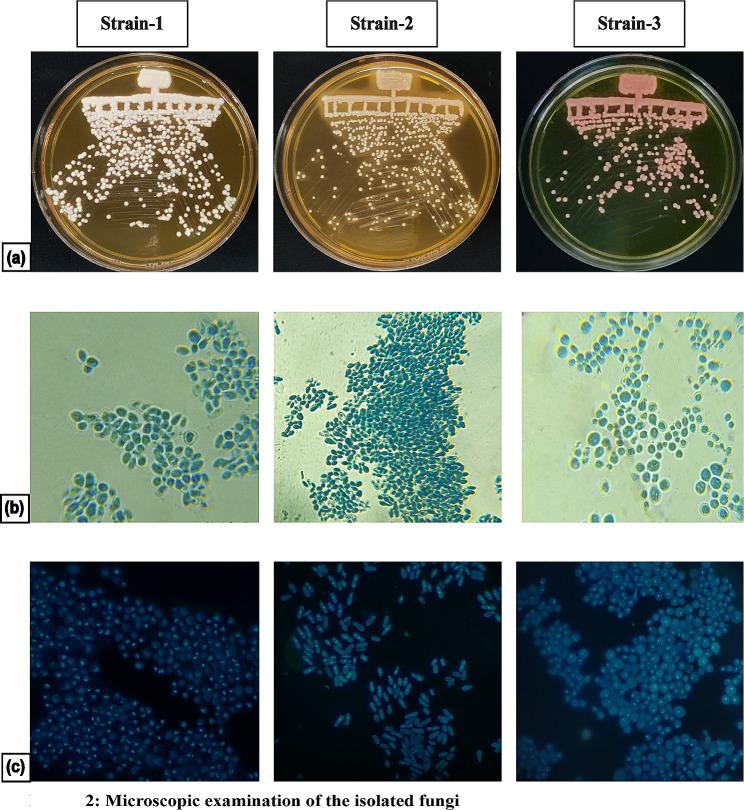
https://cdn.ncbi.nlm.nih.gov/pmc/blobs/acca/10879058/d6958ab43a3b/13568_2024_1674_Fig2_HTML.jpg

皮肤微生物群中的真菌共存:一项涉及马拉色菌、念珠菌和红酵母的研究。
Fungal coexistence in the skin mycobiome: a study involving Malassezia, Candida, and Rhodotorula.
作者信息
Naik Bharati, Sasikumar Jayaprakash, B Vishal, Das Shankar Prasad
机构信息
Cell Biology and Molecular Genetics, Yenepoya Research Centre, Yenepoya (Deemed to be University), Mangalore, 575018, India.
Department of Dermatology, Venereology and Leprosy (DVL), Yenepoya Medical College Hospital (YMCH), Yenepoya (Deemed to be University), Mangalore, 575018, India.
出版信息
AMB Express. 2024 Feb 20;14(1):26. doi: 10.1186/s13568-024-01674-8.
Evidence of fungal coexistence in humans points towards fungal adaptation to the host environment, like the skin. The human commensal Malassezia has evolved, especially residing in sebum-rich areas of the mammalian body where it can get the necessary nutrition for its survival. This fungus is primarily responsible for skin diseases like Pityriasis versicolor (PV), characterized by hypo or hyperpigmented skin discoloration and erythematous macules. In this manuscript, we report a 19-year-old healthy female who presented with a one-year history of reddish, hypopigmented, asymptomatic lesions over the chest and a raised erythematous lesion over the face. Upon clinical observation, the patient displayed multiple erythematous macules and erythematous papules over the bilateral malar area of the face, along with multiple hypopigmented scaly macules present on the chest and back. Based on the above clinical findings, a diagnosis of PV and Acne vulgaris (AV) was made. Interestingly, the patient was immunocompetent and didn't have any comorbidities. Upon isolation of skin scrapings and post-culturing, we found the existence of three fungal genera in the same region of the patient's body. We further went on to confirm the identity of the particular species and found it to represent Malassezia, Rhodotorula, and Candida. We report how Malassezia, the predominant microbial resident skin fungus, coexists with other fungal members of the skin mycobiome. This study on an applied aspect of microbiology also shows how important it is to identify the fungal organism associated with skin infections so that appropriate therapeutics can be advised to avoid cases of relapse.
人类体内真菌共存的证据表明真菌已适应宿主环境,如皮肤。人类共生菌马拉色菌已经进化,尤其栖息于哺乳动物身体富含皮脂的区域,在那里它能够获取生存所需的营养。这种真菌主要引发诸如花斑糠疹(PV)等皮肤病,其特征为皮肤色素减退或色素沉着以及红斑。在本手稿中,我们报告了一名19岁健康女性,她胸部有一年的红色、色素减退、无症状皮损病史,面部有一个凸起的红斑性皮损。临床观察发现,患者面部双侧颊部区域有多个红斑性斑疹和红斑性丘疹,胸部和背部有多个色素减退的鳞屑性斑疹。基于上述临床发现,诊断为花斑糠疹和寻常痤疮(AV)。有趣的是,该患者免疫功能正常且没有任何合并症。在分离皮肤刮屑并进行培养后,我们发现在患者身体的同一区域存在三种真菌属。我们进一步确认了特定物种的身份,发现其为马拉色菌、红酵母属和念珠菌属。我们报告了主要的皮肤常驻真菌马拉色菌如何与皮肤真菌群落的其他真菌成员共存。这项关于微生物学应用方面的研究还表明,识别与皮肤感染相关的真菌生物体以提供适当的治疗建议以避免复发情况是多么重要。